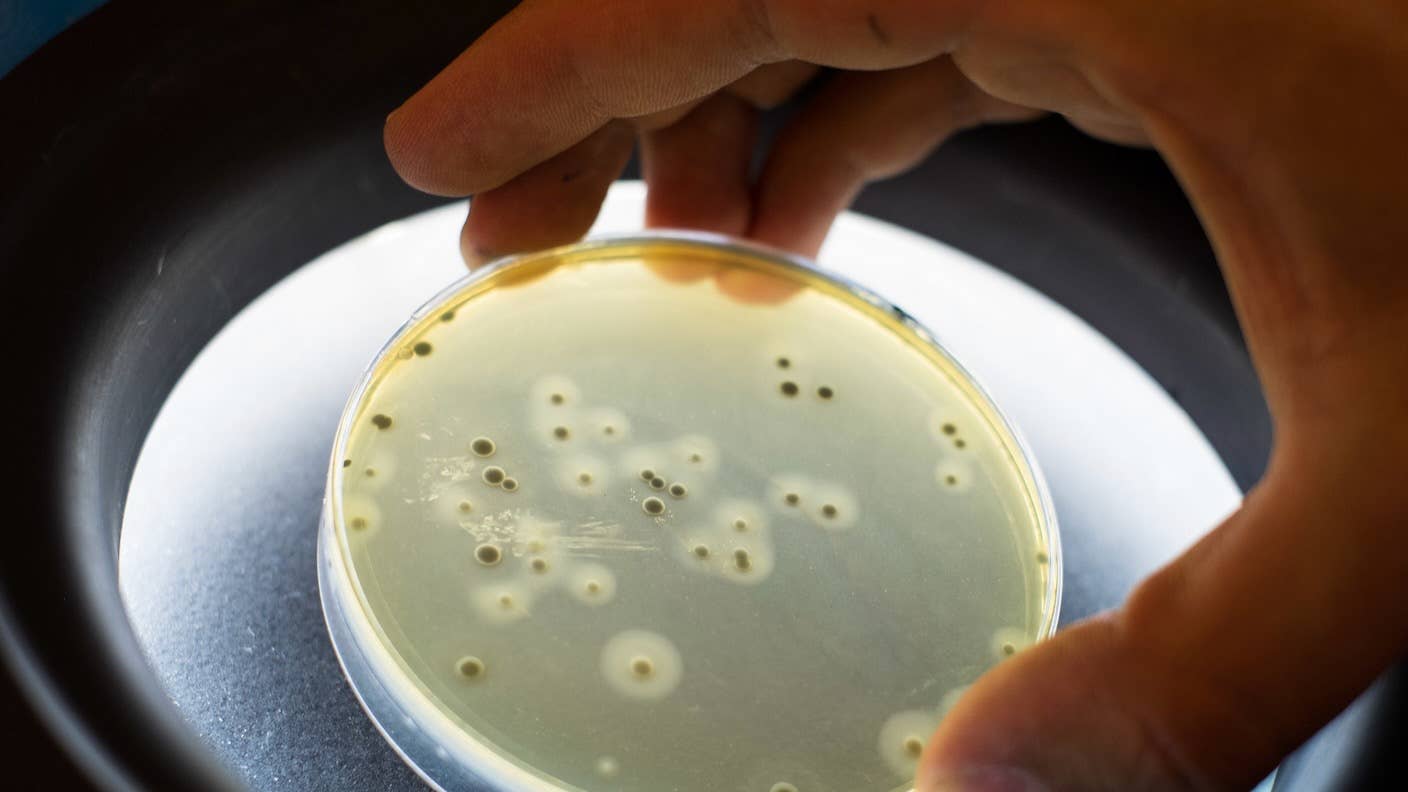
staph bacteria petri dish

These Scientists Are Battling Dangerous Superbugs With a ChatGPT-Like AI
Share
Bacteria and antibiotics have been in a roughly century-long game of cat and mouse. Unfortunately, bacteria are gaining the upper hand.
According to the World Health Organization, antibiotic resistance is a top public health risk that was responsible for 1.27 million deaths across the globe in 2019. When repeatedly exposed to antibiotics, bacteria rapidly learn to adapt their genes to counteract the drugs—and share the genetic tweaks with their peers—rendering the drugs ineffective.
Superpowered bacteria also torpedo medical procedures—surgery, chemotherapy, C-sections—adding risk to life-saving therapies. With antibiotic resistance on the rise, there are very few new drugs in development. While studies in petri dishes have zeroed in on potent candidates, some of these also harm the body’s cells, leading to severe side effects.
What if there’s a way to retain their bacteria-fighting ability, but with fewer side effects? This month, researchers used AI to reengineer a toxic antibiotic. They made thousands of variants and screened for the ones that maintained their bug-killing abilities without harming human cells.
The AI used in the study is a large language model similar to those behind famed chatbots from Google, OpenAI, and Anthropic. The algorithm sifted 5.7 million variants of the original antibiotic and found one that maintained its potency but with far less toxicity.
In lab tests, the new variant rapidly broke down bacteria “shields”—a fatty bubble that keeps the cells intact—but left host cells undamaged. Compared to the original antibiotic, the newer version was far less toxic to human kidney cells in petri dishes. It also rapidly eliminated deadly bacteria in infected mice with minimal side effects. The platform can also be readily adapted to screen other drugs in development, including those for various types of cancers.
“We have found that large language models are a major step forward for machine learning applications in protein and peptide engineering,” said Dr. Claus Wilke, a University of Austin biologist and data scientist and an author on the study, in a press release.
Insane in the Membrane
Antibiotics work in several ways. Some disrupt bacteria’s ability to create proteins. Others inhibit the copying of their genetic material, halting reproduction. Yet more selectively destroy their metabolisms.
Each strategy took years to research and even longer to develop safe and effective antibiotics. But bacteria rapidly evolve to evade these drugs.
Overuse of antibiotics in medicine and agriculture is giving rise to “superbugs” resistant to even the toughest current drugs. Once a strain of bacteria learns to evade a mechanism—say, hindering protein production—it readily blocks other drugs that target the same strategy.
Resistance can also rapidly spread through a bacterial population. Unlike our genetic material, which is encapsulated inside a nut-like structure, bacterial DNA freely floats around in their cells. Genetic changes—for example, those that allow bacteria to evade antibiotics—can be transmitted to other similar bacteria through temporary biological “tunnels” that literally connect the two cells. In other words, antibiotic resistance spreads fast.
That is, if given the chance.
For antibiotic resistance to develop, the bacteria need to survive the initial onslaught. Extremely deadly treatments, including a class called antimicrobial peptides, wipe out bacteria before they can adapt. These drugs rapidly break up the fatty protective barrier surrounding all bacterial cells. Decades in the works, scientists have made many of these molecules.
The problem? They also harm the membranes protecting our own cells, resulting in toxicity that makes most of them unusable in people. Although a library of these hyper-potent antibiotic drugs already exists, like underperforming ball players, they’ve mostly been benched.
Safe and Sound
The new study aimed to rehabilitate antimicrobial peptides by tweaking one called Protegrin-1. While extremely efficient at killing bacteria, it’s too toxic for human use. The researchers wanted to see if they could dial down side effects but maintain its bacteria-killing prowess.
Be Part of the Future
Sign up to receive top stories about groundbreaking technologies and visionary thinkers from SingularityHub.


Led by Dr. Bryan Davies, the team had previously developed a system to rapidly screen hundreds of thousands of peptides to see if they could kill harmful bacteria.
Called SLAY, for Surface Localized Antimicrobial Display, the system looks like a bunch of tetherballs with one end of each fixed to a biological surface and the other—this is the antimicrobial peptide—floating around to capture bacteria.
The researchers then engineered over 5.7 million Protegrin-1 variants. “This is a massive increase in diversity over the 18 single mutants” in previous studies, wrote the authors.
Next, they turned to AI large language models. Known for their ability to generate text, audio, and videos, this type of algorithm learns by ingesting terabytes of data and can spit out responses based on a specific prompt. While mostly used to generate text, scientists have increasingly embraced their capacity to “dream up” new proteins or other drugs.
The study used several prompts to guide the AI’s search: Things like, the drug has to target bacteria membranes, and it needs to break those up without harming human cells. The AI screened the available pool of variants and found one that hit the sweet spot—a new version dubbed bacterially selective Protegrin-1.2—that met all the guidelines.
Tested in petri dishes, the variant rapidly broke down membranes in Escherichia coli, a common type of bacteria often used for research, within half an hour. Human red blood cells, meanwhile, thrived under the same circumstances, even when exposed to levels 100 times higher than the bacteria. Rather than indiscriminatingly killing off both bacteria and human cells, the AI-approved antibiotic zeroed in on the pathogen.
Protegrin-1 has a reputation for causing kidney harm. The team pitted Protegrin-1.2 against the original and Colistin, an antibiotic used as a last-resort treatment, in cultured human kidney cells. The variant topped the others in safety measures, showing less cell membrane damage.
The team also treated mice infected with a type of multidrug-resistant bacteria—which roams hospitals—with the AI-selected antibiotic. Six days later, critters treated with the new version had lower levels of bacteria in multiple organs compared to untreated mice. Some had zero signs of infection at all. Compared to Protegrin-1, the new version “is significantly less toxic to mice,” wrote the authors.
Although the study focused on antibiotics, the team envisions using a similar strategy to reengineer other drugs previously thought too toxic for humans. Recently, another team used AI to determine the structure of small chemicals useful in antibiotic and cancer therapies but previously discarded by chemists as unusable in safe and effective medications.
“Many use cases that weren’t feasible with prior approaches are now starting to work. I foresee that these and similar approaches are going to be used widely for developing therapeutics or drugs going forward,” said Wilke.
Image Credit: x / x
Dr. Shelly Xuelai Fan is a neuroscientist-turned-science-writer. She's fascinated with research about the brain, AI, longevity, biotech, and especially their intersection. As a digital nomad, she enjoys exploring new cultures, local foods, and the great outdoors.
Related Articles

New Immune Treatment May Suppress HIV—No Daily Pills Required

Study: AI Chatbots Choose Friends Just Like Humans Do

Scientists Just Developed a Lasting Vaccine to Prevent Deadly Allergic Reactions
What we’re reading